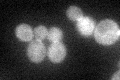
YER155C
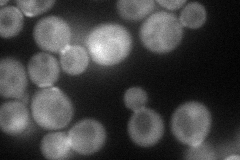
YER155C
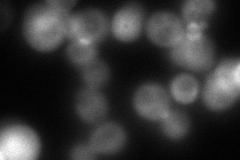
YER155C
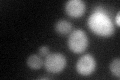
YER155C
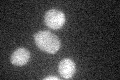
YER155C

View description
Rho GTPase activating protein (RhoGAP) involved in the control of cytoskeleton organization and cellular morphogenesis; required for bud emergence
Localization:
Intensity:
Fold change:
Significance:
-
C’ GFP library in SD
cytosol:bud neckN/A -
N' NOP1pr-GFP in SD
cytosol,bud76.993 -
N' TEF2pr-mCherry in SD
cytosol,bud26.692 -
N' NATIVEpr-GFP in SD

below threshold23.1992 -
N' TEF2pr-VC and Cyto-VN in SD

cytosol36.4708 -
C’ GFP library in SD+DTT
cytosol.bud neck40.771.05No -
C’ GFP library in SD+H2O2

cytosol.bud neck38.50.99No -
C’ GFP library in Starvation Media
cytosol,bud neck29.610.76No -
C’ GFP library on the background of Pup2-DaMP

cytosol:bud neck -
C’ GFP library on the background of CCT mutant

cytosol:bud neck46.46441.20043No
